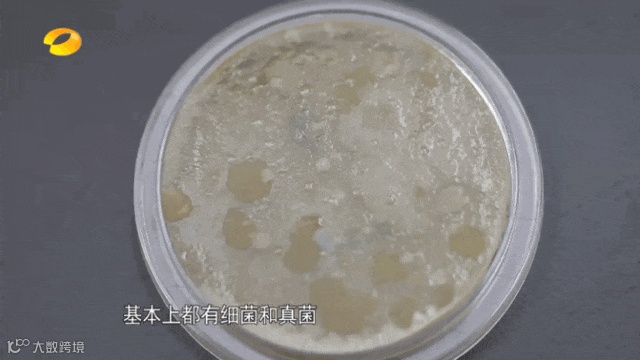

平时做家务时,抹布是必不可少的清洁工具,小到碗筷,大到家具,都需要它来辅助打扫。
你可能没想到,这块“娇小”的抹布其实是个优秀的细菌培养基,身上包裹着数亿病菌。

很多人以为只要用洗洁精冲洗后,抹布就干净了。实际上,它远比你想象得要脏。

抹布并不是用到发烂发臭才要换。
有实验证明,抹布其实是家中大肠杆菌等致病菌超标的重灾区。这么一想,到底是越洗越干净了还是让细菌分布得更均匀了都不知道。
给大家推荐一种神奇抹布,MAYNOS三层加厚银丝洗碗布!去污能力更好,还干得快,不容易藏污纳垢!

它真的太好用了!
亲水疏油,一擦即净,干湿两用不留痕迹,还干得快,简直是心中完美抹布。

抖音卖爆的银丝抹布,随便一搜都是100W的销量!
注意!这不是同款!是升级款!三层加厚不加价!

洗碗布重要是清洁力!
我们这款两层银丝之间添加了海绵夹层,更易于揉出丰富的泡沫,泡沫越多,清洁力越强
利用泡沫来浸润、溶解、洗去油腻污渍!!

很柔软完全不伤手~不仅能刷锅刷碗,还可以擦台面、擦电器,清洁效果甩普通抹布好几条街!


可以代替钢丝球!不仅不伤锅不留痕迹,而且能够轻轻松松的擦干净,还能反复使用!
花一点小钱,就让家人孩子的健康得到保护挺值的
厨房清洁是全家最难的地方,为了针对厨房灶台的钢面和不锈钢等材质
参考了钢丝球的质感,舍弃了钢丝球的硬度,改成了丝网设计的金属丝抹布


之所以说它是不锈钢污渍克星,是因为金属丝表面摩擦张力很足
本身金属丝附带清洁属性,但是比普通抹布多了柔软的摩擦力,所谓是”柔软摩擦,深度清洁”的效果

因为是丝制设计的,预留网眼很多可以揉搓出丰富的泡沫,而且网眼结构稳定,随意揉搓不会让抹布变形

它的金属纤维非常柔软,还能去土豆、胡萝卜、红薯等带皮食物表面的杂质
只需要轻轻擦拭,带有污渍的食材/物品就会变得干净滑腻



网面透气好晾晒,时间久了也不会发霉,通风出一会就干了,不容易滋生细菌

一包有5片,独立的包装,拿取方便

距离过年不到一个月,年底大扫除要提上日程了
大扫除耗时耗力的莫过于各种洗洗擦擦,[MAYNOS 三层加厚银丝洗碗布]帮你轻松搞定所有顽固污垢!

比钢丝球柔和,也不会留下银丝残留在锅具上,强力去污,不伤涂层!



